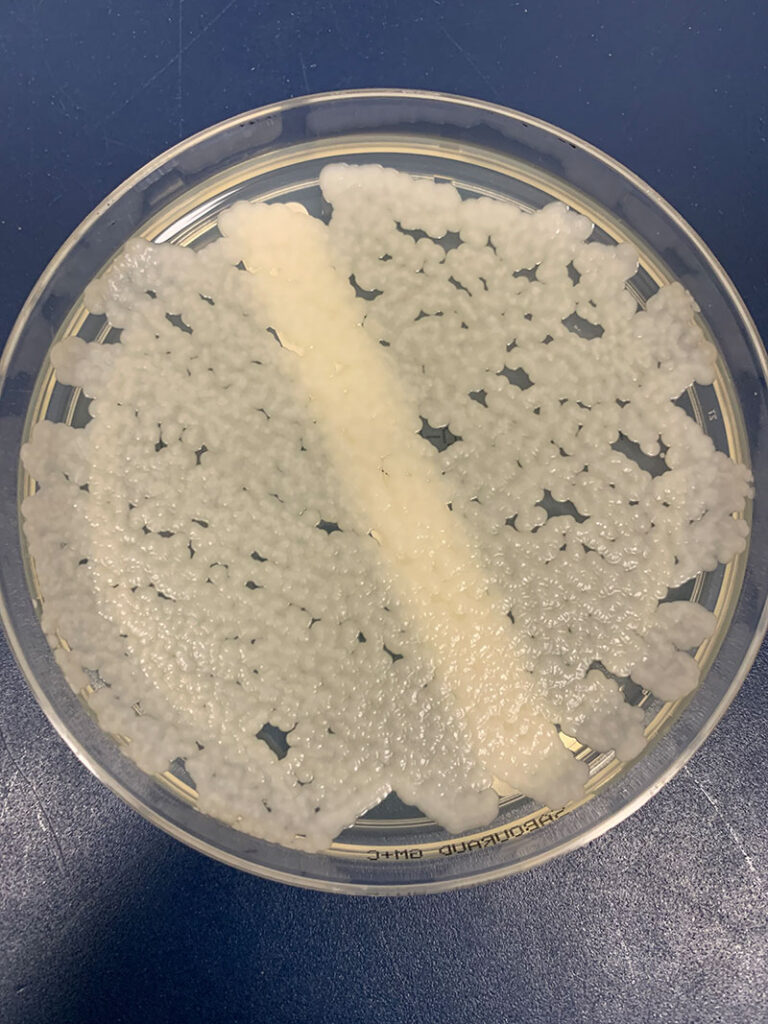

Nelle cavalle da riproduzione, le infezioni del tratto genitale possono portare principalmente a infertilità, aborti e alla nascita di puledri deboli con setticemia.
Per questo motivo, è necessario l’esame batteriologico dei tamponi cervicali o uterini prima dell’inseminazione di una cavalla, sia naturale che artificiale. Oltre alla coltura batteriologica, può essere utile anche testare eventuali infestazioni da lieviti e muffe.
Meccanismi di protezione contro le infezioni
Oltre alle barriere fisiche come la chiusura vulvare, lo sfintere vestibolo-vaginale e la cervice, anche i meccanismi immunitari locali prevengono la colonizzazione di microrganismi patogeni (facoltativi).
Se queste barriere fisiche non sono intatte, ad esempio dopo un travaglio difficile, possono verificarsi pneumovagina o ritenzione urinaria.
I patogeni possono quindi colonizzare queste zone più facilmente.
Difetti nelle caratteristiche anatomiche delle grandi corna uterine, del miometrio, del legamento latum utero e alterazioni degenerative dell’apporto vascolare e del drenaggio linfatico possono influire negativamente sull’”autopulizia” della mucosa uterina.
Difesa immunitaria
Dopo l’infezione sperimentale con Streptococcus equi ssp. zooepidemicus, le cavalle intatte sono state in grado di eliminare il patogeno entro poche ore. Nelle cavalle più anziane, rimaste sterili per un periodo di tempo più lungo, l’eliminazione dei patogeni introdotti Streptococcus equi ssp. zooepidemicus e Pseudomonas aeruginosa ha richiesto tempi considerevolmente più lunghi.
Meccanismi di difesa umorale
Le immunoglobuline dominanti, IgG e IgA secretorie, sono prodotte nell’endometrio. La concentrazione di immunoglobuline differisce solo marginalmente tra cavalle suscettibili all’endometrite e quelle immuni. Le cavalle suscettibili all’endometrite erano meno efficienti nell’eliminare gli streptococchi introdotti con opsonine durante l’infezione acuta e quindi meno capaci di avviarne l’eliminazione.
Risposta immunitaria cellulare
Chemiotatticamente, i neutrofili possono reagire a batteri, endotossine, sperma, diluenti del seme e persino acqua sterile, senza differenze significative tra cavalle suscettibili all’endometrite e quelle non suscettibili.
La stimolazione cellulare dopo l’accoppiamento può portare a una reazione infiammatoria permanente in alcune cavalle dovuta alla proteina estranea, nota come endometrite permanente indotta dall’accoppiamento (PMIE).
Questa reazione infiammatoria persistente, con un’aumentata presenza di neutrofili, è ulteriormente stimolata dalla presenza di batteri.
È innescata da una reazione locale all’antigene primario, con produzione locale di mediatori infiammatori, in particolare prostaglandina E2, e aumento dell’afflusso di neutrofili insieme alle proteine sieriche. L’attività fagocitaria dei neutrofili è massima durante l’estro.
- Immagine: envatoelements
-
Fig. 1: Candida parapsilosis
Immagine: Laboklin
-
Fig. 2: Valutazione dell’esame micologico del 2024, rilevazione positiva
7,4% (n = 101)
Immagine: Laboklin
-
Fig. 3: Isolati di Candida per concentrazione
Immagine: Laboklin
Diagnosi delle infezioni fungine
I campioni citologici (le biopsie della mucosa uterina sono più affidabili) forniscono indicazioni sullo stato del ciclo e della mucosa, nonché su eventuali segni di infiammazione. I batteri possono essere rilevati direttamente al microscopio senza ulteriore identificazione della specie.
Se il profilo delle cellule infiammatorie suggerisce un’infezione fungina, è possibile utilizzare colorazioni specifiche per determinare se si tratti di un lievito o di un fungo.
Per gli esami colturali, il campione deve essere prelevato dalla cervice o dall’utero utilizzando, se possibile, uno speculum sterile.
Da questo campione è possibile ottenere colture sia batteriologiche che micologiche.
Per la coltura micologica, si utilizza agar Sabouraud destrosio con cloramfenicolo e gentamicina per inibire la flora batterica.
L’incubazione avviene a 36 °C per 48 ore, seguita dalla prima lettura. Le colture negative vengono nuovamente controllate per la crescita fungina dopo ulteriori 5 giorni di incubazione.
I lieviti e i funghi filamentosi vengono differenziati mediante spettrometria di massa MALDI-TOF e microscopicamente dopo colorazione con soluzione di lattofenolo blu cotone.
Risultati delle nostre indagini
Su 1.365 tamponi cervicali e uterini esaminati micologicamente, il 7,4% (n = 101) ha mostrato una crescita positiva sul terreno di coltura fungino.
Di questi, i lieviti della specie Candida spp. sono stati isolati nel 61% dei casi.
Nella differenziazione, Candida parapsilosis (Fig. 1) ha dominato il complesso Candida con il 46%, mentre il 16% e il 17% hanno mostrato livelli moderati o elevati di questo lievito (Fig. 2 e 3).
Altre specie di Candida sono state isolate solo sporadicamente. Funghi filamentosi, tra cui Aspergillus e Penicillium, così come funghi neri come Alternaria alternata, sono stati coltivati solo in casi isolati, solitamente a basse concentrazioni.
Valutazione
Oltre al rilevamento di lieviti e funghi, è necessario considerare anche i risultati clinici.
Si sospetta un’endometrite da lieviti o funghi se l’endometrite cronica non migliora o migliora solo temporaneamente dopo un trattamento antibiotico.
È spesso presente un utero molto disteso con secrezione torbida. La mucosa cervicale e l’endometrio appaiono nettamente infiammati, con una colorazione rosso sporco. Bassi livelli di lieviti senza alterazioni cliniche sono generalmente trascurabili. Il rilevamento di un basso livello di funghi è più probabilmente interpretato come contaminazione durante la raccolta del campione.
In molti casi, l’endometrite causata da lieviti o funghi è preceduta da un trattamento intrauterino con antibiotici per trattare un’infiammazione causata da batteri. Gli antibiotici applicati possono danneggiare la mucosa, mentre lieviti e funghi possono essere introdotti dall’esterno durante il trattamento intrauterino. Si discute anche se l’uso di fluidificanti del liquido seminale contenenti antibiotici possa portare a una proliferazione fungina.
Terapia
Il lavaggio viene utilizzato per pulire il lume uterino ed eliminare detriti cellulari, come neutrofili morti, insieme a microrganismi e altri prodotti infiammatori. Il liquido induce contrazioni uterine e pulizia a causa della temporanea irritazione della mucosa.
Per l’irrigazione, vengono utilizzate soluzioni elettrolitiche bilanciate riscaldate come la soluzione di Ringer o soluzioni saline.
A queste soluzioni possono essere aggiunti antisettici blandi, come lo iodio-povidone o la clorexidina. È necessario assicurarsi che vengano utilizzati in forma diluita; in caso contrario, potrebbe verificarsi una grave infiammazione o persino una necrosi della mucosa. La soluzione di povidone-iodio deve essere utilizzata a una concentrazione massima dello 0,05% (5 ml di una soluzione di povidone-iodio al 10% in 1 litro di soluzione salina) e la clorexidina digluconato a una concentrazione massima dello 0,25%.
L’uso di dimetilsolfossido (DMSO) come agente chimico irritante per rimuovere il tessuto endometriale infiammato è piuttosto discutibile dal punto di vista del benessere animale. Dopo l’irrigazione, si può prendere in considerazione l’uso di antimicotici. Attualmente, nessun principio attivo è approvato per l’uso sistemico o intrauterino nei cavalli.
Diverse sostanze, come nistatina, amfotericina B o clotrimazolo, vengono utilizzate per via intrauterina per il trattamento di infezioni fungine o da lieviti (uso off-label).
La nistatina, da 0,5 a 2,5 milioni di unità disciolte in 100-250 ml di acqua sterile, è adatta per i lieviti. Essendo scarsamente solubile in acqua, deve essere preparata immediatamente prima dell’applicazione e portata in sospensione agitando energicamente.
Il miconazolo, 200-700 mg in 40-60 ml di soluzione salina sterile al giorno per un massimo di 10 giorni, è risultato essere il più efficace contro la Candida.
La terapia con antimicotici deve essere continuata per almeno 7-10 giorni.
Se necessario, è possibile eseguire un antimicogramma per determinare la sensibilità agli agenti antifungini.
Conclusioni
Anche gli stalloni tenuti isolati per lunghi periodi di tempo dovrebbero essere sottoposti a un esame micologico nell’ambito della valutazione dell’igiene riproduttiva. La probabilità di eliminare con successo il patogeno rimane incerta nonostante il trattamento.
Dott. Anton Heusinger
Esami/profili relativi all’igiene della riproduzione
- Igiene della riproduzone
- Igiene della riproduzone + micologia
- Igiene della riproduzone + CEM (Taylorella equigenitalis)
- CEM: coltura o PCR
- Profili CEM per fattrici e stalloni